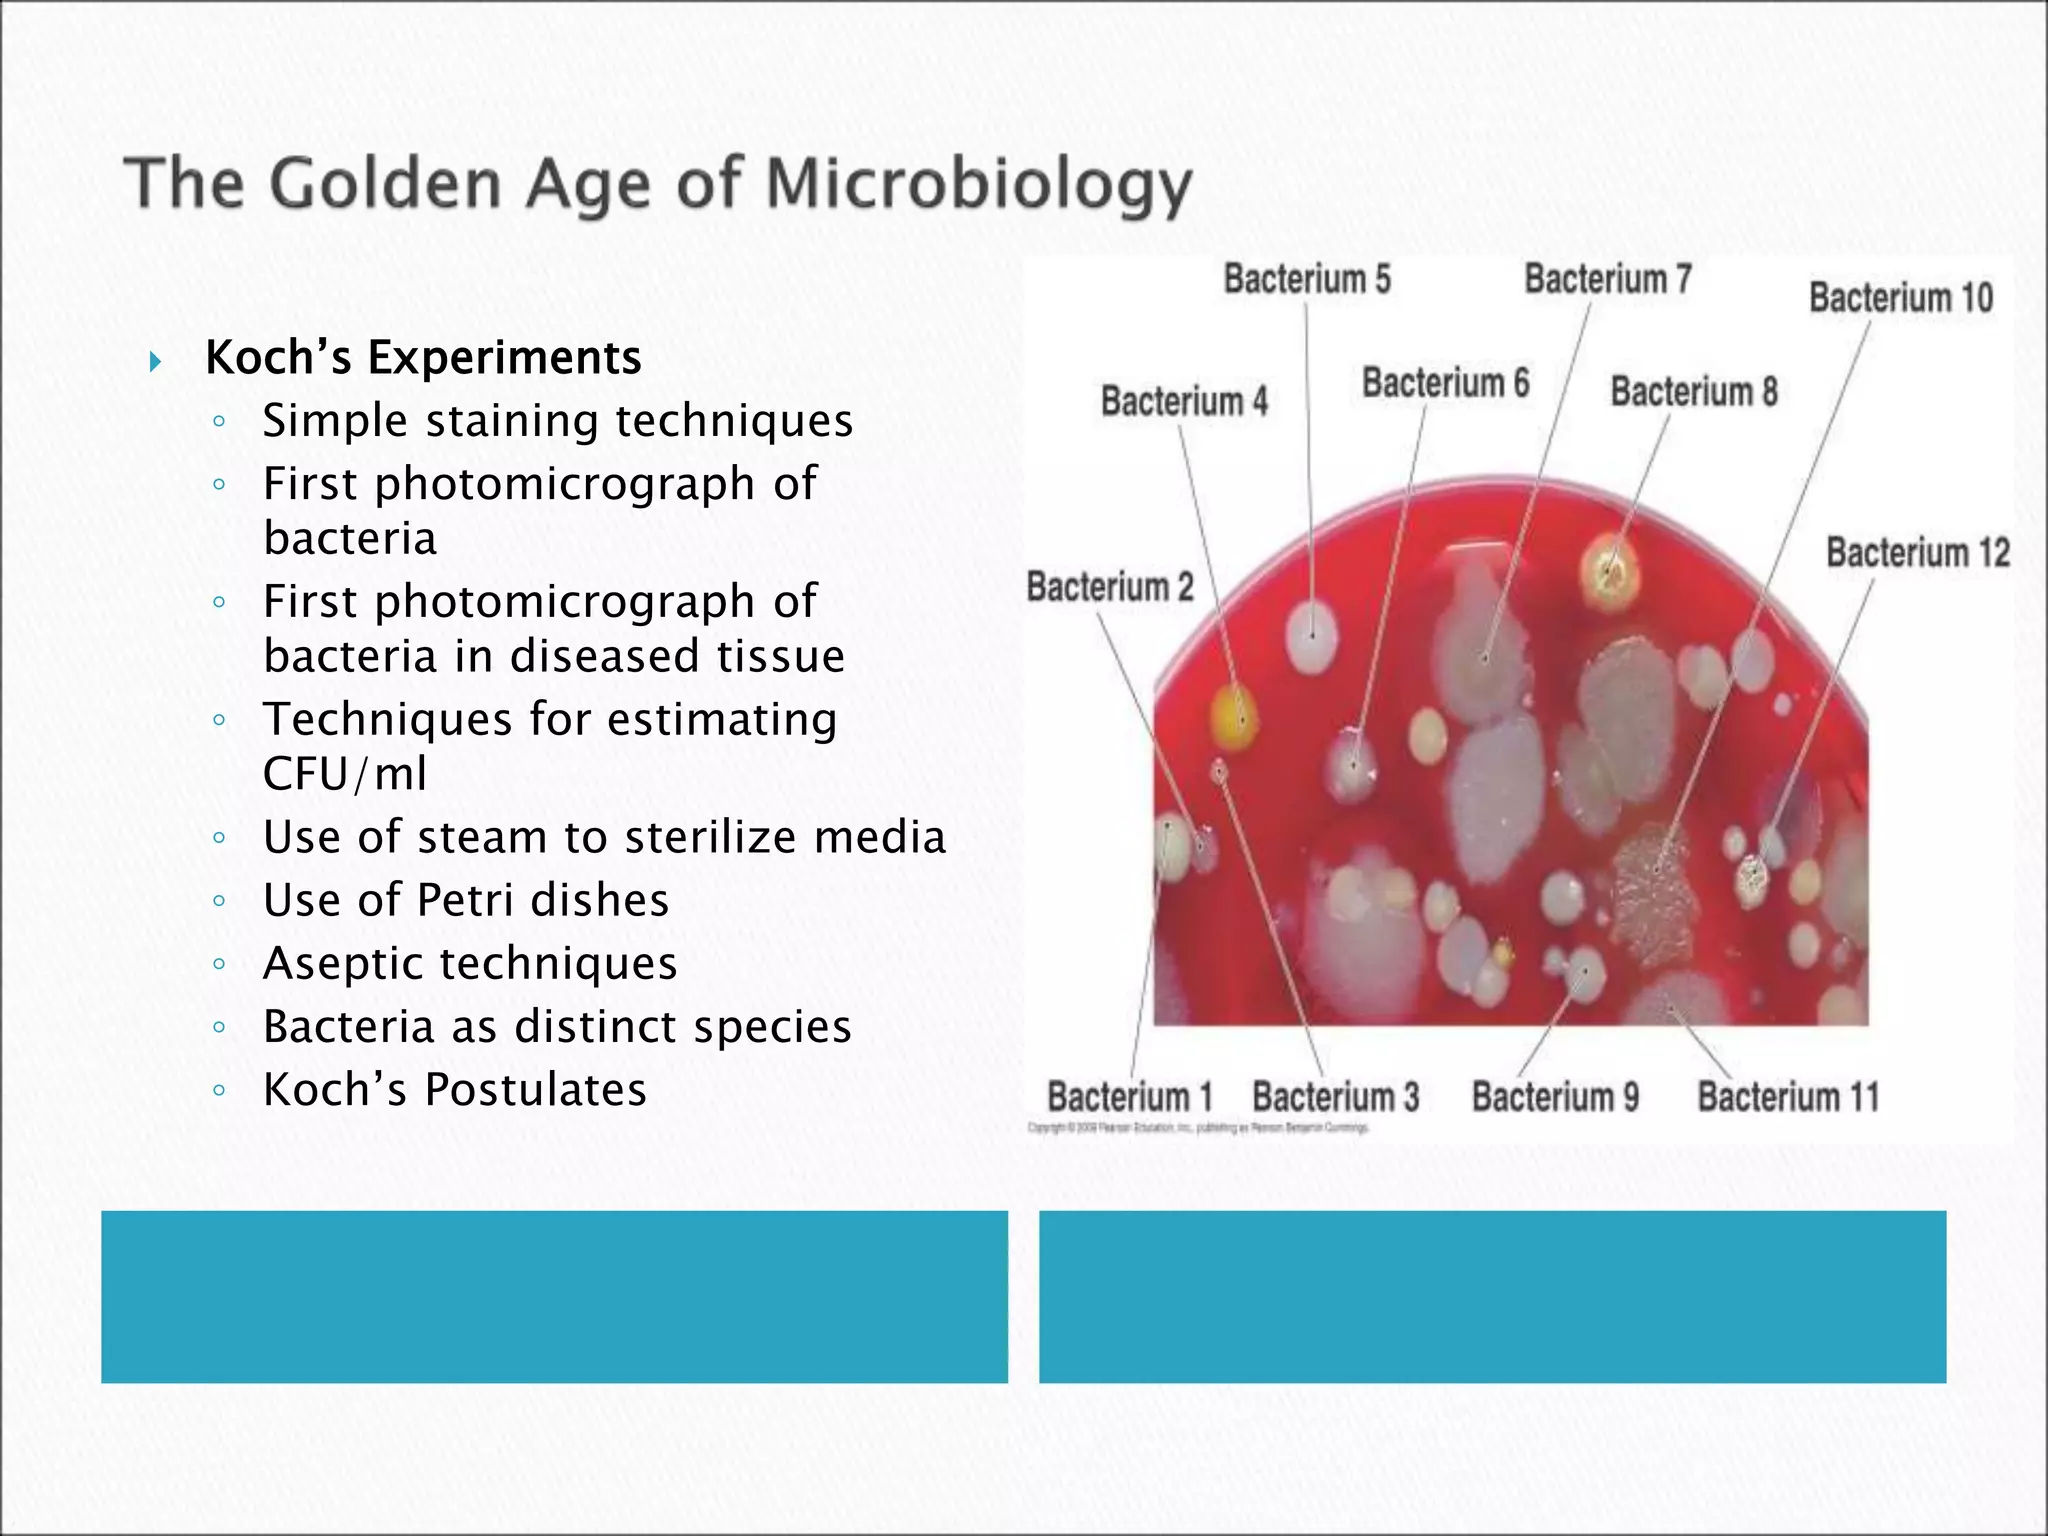
 Koch’s Experiments
◦ Simple staining techniques
◦ First photomicrograph of
bacteria
◦ First photomicrograph of
bacteria in diseased tissue
◦ Techniques for estimating
CFU/ml
◦ Use of steam to sterilize media
◦ Use of Petri dishes
◦ Aseptic techniques
◦ Bacteria as distinct species
◦ Koch’s Postulates
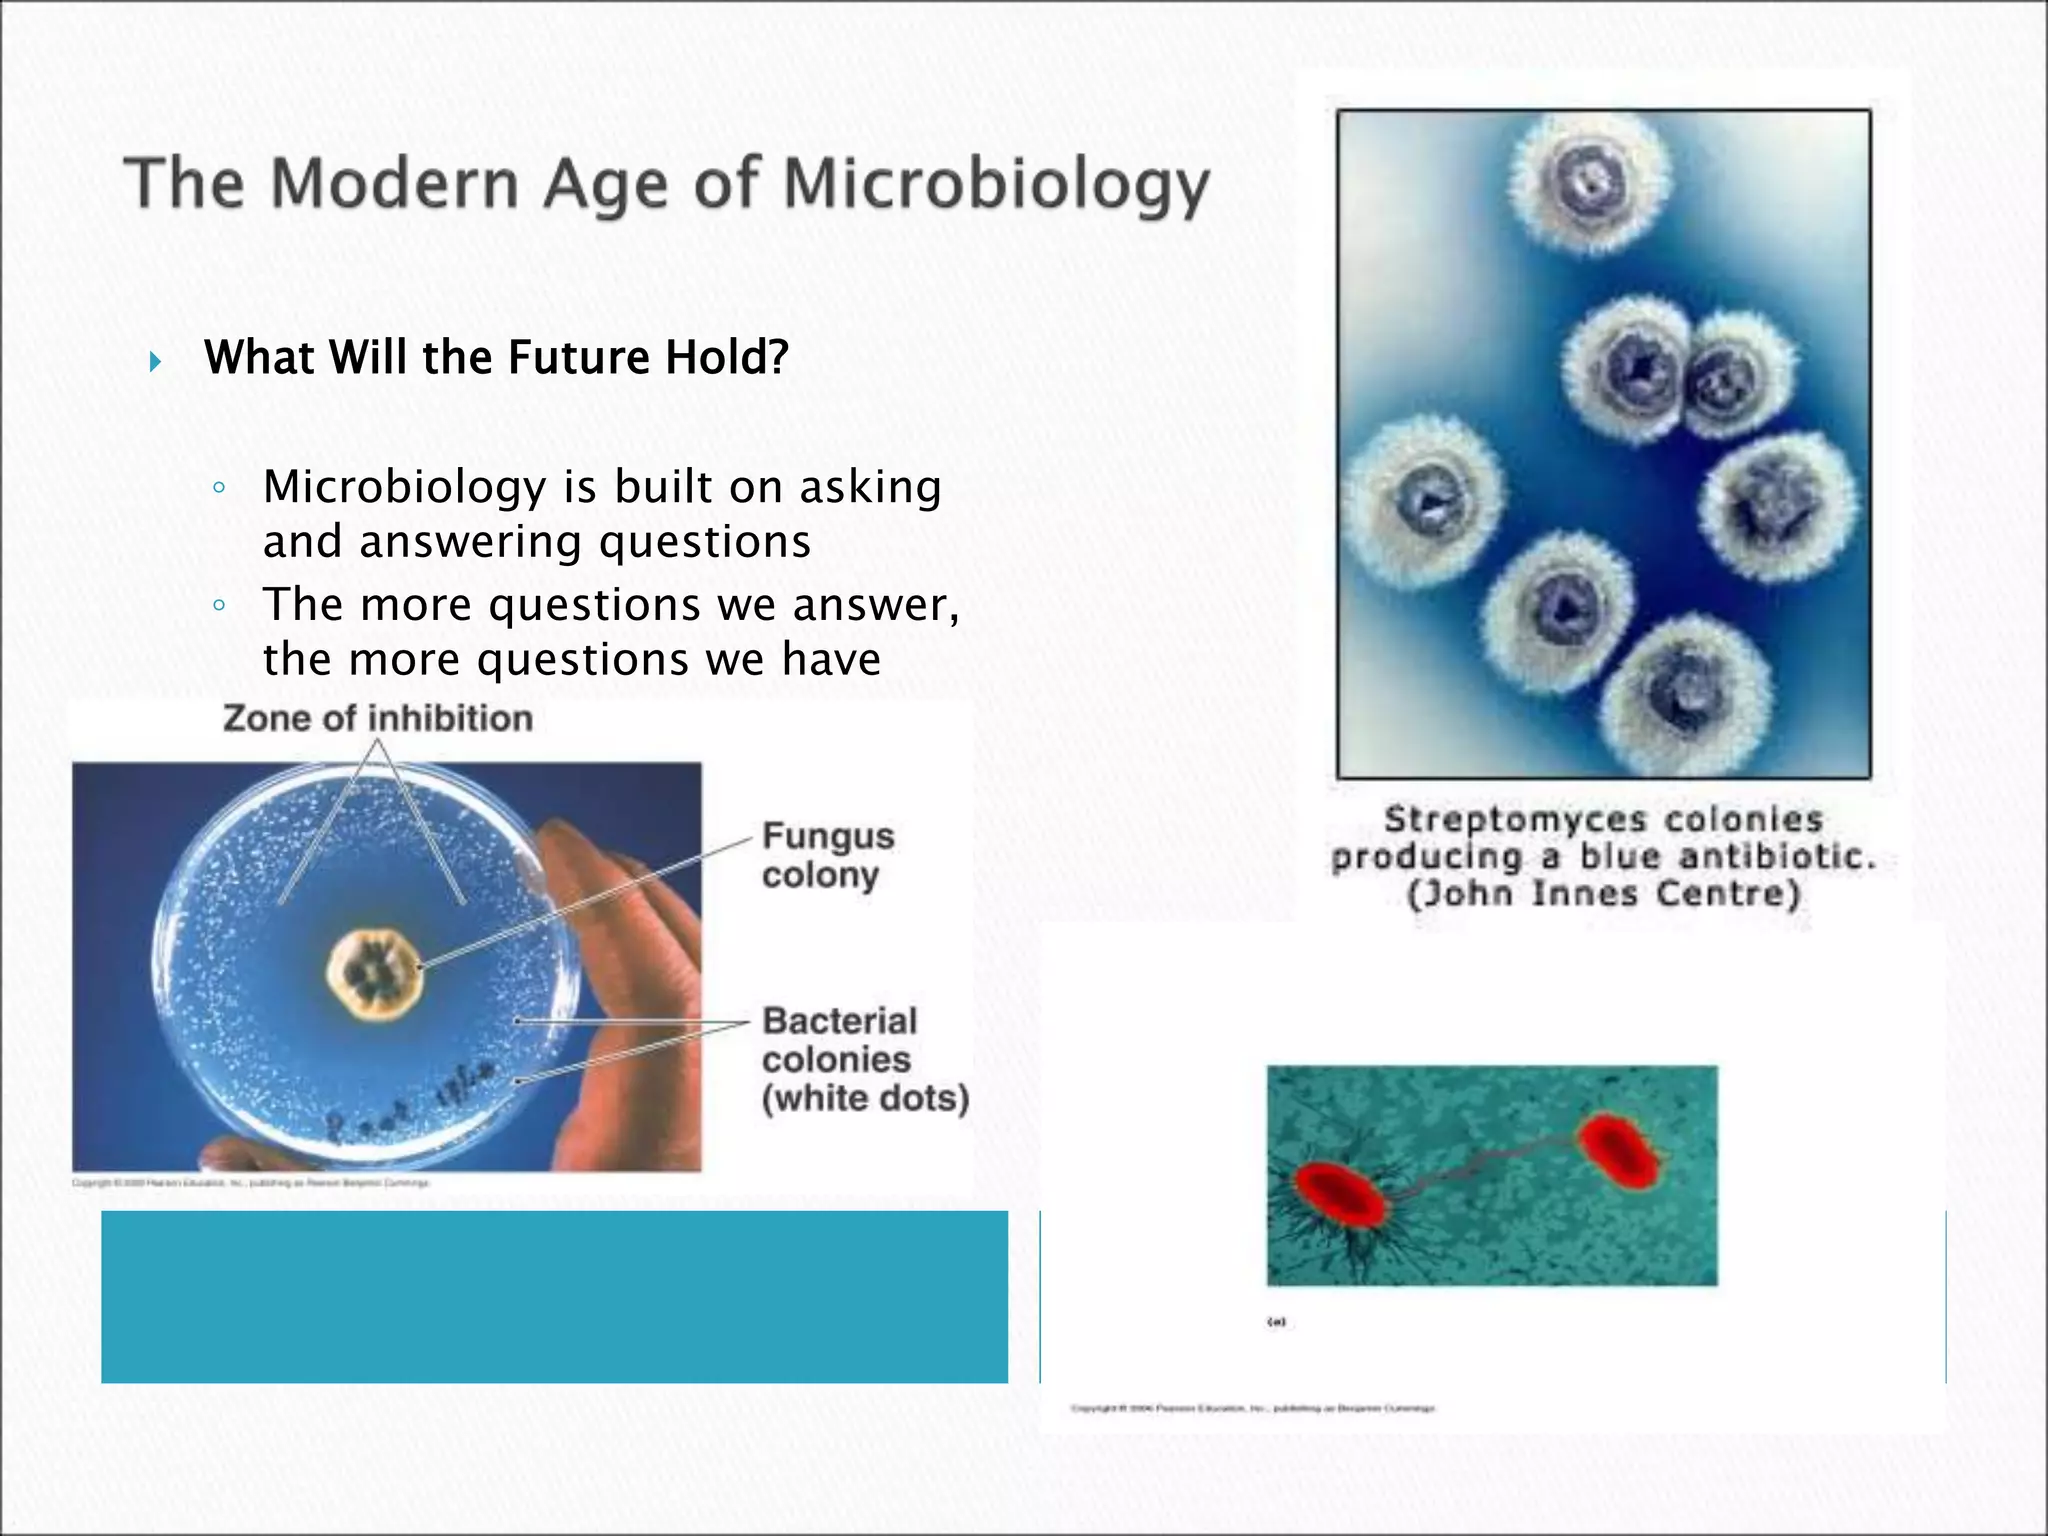
 What Will the Future Hold?
◦ Microbiology is built on asking
and answering questions
◦ The more questions we answer,
the more questions we have

This document provides an overview of microbiology and the classification of microorganisms. It discusses the early history of microbiology including the development of germ theory and experiments by scientists like Redi, Pasteur, and Koch. Microbes are classified into six categories: fungi, protozoa, algae, bacteria, archaea, and small animals. Bacteria and archaea are further described. The document also discusses topics like biochemistry, genetics, emerging diseases, antibiotic resistance, and the future of microbiology.